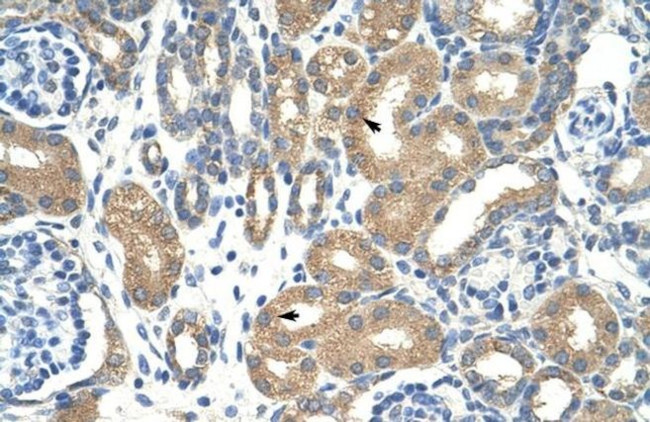
APOBEC3D Antibody in Immunohistochemistry (Paraffin) (IHC (P))

Search
Invitrogen
APOBEC3D Polyclonal Antibody
{{$productOrderCtrl.translations['antibody.pdp.commerceCard.promotion.promotions']}}
{{$productOrderCtrl.translations['antibody.pdp.commerceCard.promotion.viewpromo']}}
{{$productOrderCtrl.translations['antibody.pdp.commerceCard.promotion.promocode']}}: {{promo.promoCode}} {{promo.promoTitle}} {{promo.promoDescription}}. {{$productOrderCtrl.translations['antibody.pdp.commerceCard.promotion.learnmore']}}
产品信息
PA5-41950
种属反应
宿主/亚型
分类
类型
抗原
偶联物
形式
浓度
规格
纯化类型
保存液
内含物
保存条件
运输条件
RRID
产品详细信息
Peptide sequence: SYTWLCYEVK IKRGRSNLLW DTGVFRGPVL PKRQSNHRQE VYFRFENHAE
Sequence homology: Human: 100%
靶标信息
This gene is a member of the cytidine deaminase gene family. It is one of a group of related genes found in a cluster, thought to result from gene duplication, on chromosome 22. Members of the cluster encode proteins that are structurally and functionally related to the C to U RNA-editing cytidine deaminase APOBEC1 and inhibit retroviruses, such as HIV, by deaminating cytosine residues in nascent retroviral cDNA.
仅用于科研。不用于诊断过程。未经明确授权不得转售。
篇参考文献 (0)
生物信息学
蛋白别名: A3D; apolipoprotein B mRNA editing enzyme, catalytic polypeptide-like 3D; apolipoprotein B mRNA editing enzyme, catalytic polypeptide-like 3E pseudogene; bK150C2.9; cytidine deaminase; DNA dC->dU-editing enzyme APOBEC-3D; probable DNA dC->dU-editing enzyme APOBEC-3D
基因别名: A3D; A3DE; APOBEC3D; APOBEC3DE; APOBEC3E; ARP6
UniProt ID: (Human) Q96AK3
Entrez Gene ID: (Human) 140564